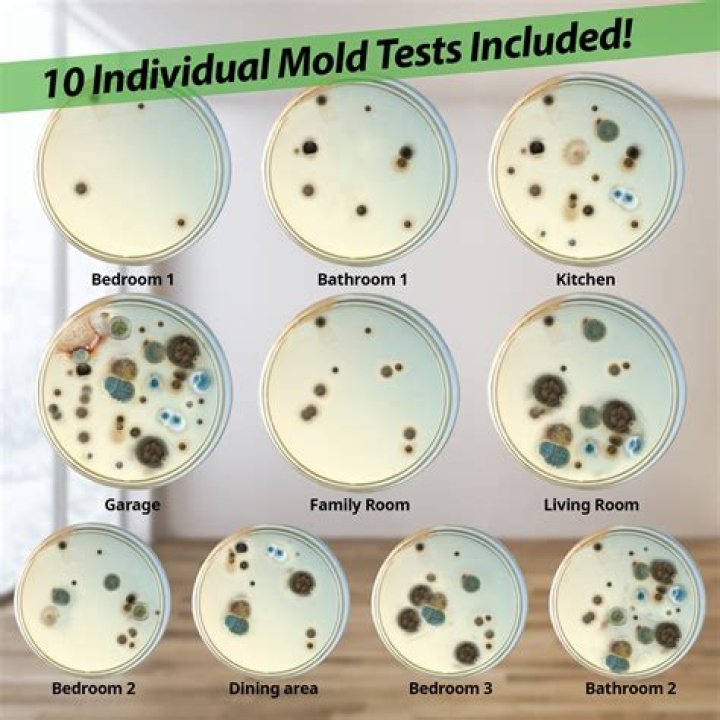

A quick test for mold can be done when you dip a swab in diluted bleach (1 part bleach, 16 parts water) and dab it on the wall. If the spot quickly lightens (or keeps coming back after cleaning), assume it's mold.What are signs of mold in your house?
Signs Your Home May Have a Mold Problem
- Rotten Smell. Is there a damp, musty odor reminiscent of the smell of old books emanating from your floors or walls? ...
- Spotted Clothing. ...
- Contaminated Carpets. ...
- Water Heater Hideaway. ...
- Allergy or Asthma Flare-Ups. ...
- Fungus in the Furniture. ...
- Warped Walls. ...
- Persistent Cough or Cold.
Are home mold test kits reliable?
The results lack enough credibility that lawyers, doctors, insurance companies, and remediation companies do not accept the results. Consumer Reports, in fact, rated four different brands of DIY mold tests “Not Recommended,” citing the following: “In some samples, the vials with media leaked over entire kit.
Is there a mold detector?
Mold testing kits help you detect and identify growing spores in your home through samples collected via the air or from the surface in question. Some give you results right away, while others ask you to package the samples and send them back to a lab for a professional examination.
Can you do mold testing yourself?
A: The Mold Armor Do-It-Yourself Mold Test Kit lets you test for the presence of mold in just 48 hours. If you find mold present in your test dish you can register your mold sample online and $40 to receive a lab analysis to determine the mold type.
9 Signs You Have Toxic Mold In Your Home
What are signs of mold sickness?
If you're sensitive to mold, you may experience the following symptoms:
- sneezing.
- nasal congestion.
- runny nose.
- skin rash.
- itching.
- watery eyes.
- asthma.
- chest tightness.
How can you tell if you have mold behind drywall?
Visible Signs of Mold
Mold can have different colors and textures, so be sure to recognize them. Mold can be black, green, gray, white, or brown. Mold can even appear orange, pink or purple when it grows behind vinyl wallpaper. Another sign of visible mold is discoloration of walls, even if it has been painted over.
Can you test air for mold?
Air samples can be used to gather data about mold spores present in the interior of a house. These samples are taken by using a pump that forces air through a collection device which catches mold spores. The sample is then sent off to a laboratory to be analyzed.
Is there an instant mold test?
The Instant Mold Test Kit includes one surface test for ten minute results, and one collection media for optional laboratory analysis.
Do air purifiers help with mold?
Air purifiers help capture mold spores from the air, preventing them from reproducing and spreading throughout your home. While air purifiers won't help treat active mold that's already present on surfaces, they are a great way to control the spread of airborne mold particles.
How much does it cost to test for mold in your house?
As a rough guideline, a mold inspection costs about the same as a regular home inspection, the kind that is done when you purchase a new home. On average, mold inspection costs $300 to $400 for small to medium-sized houses (below 4,000 square feet). Above 4,000 square feet, the cost increases to the $700 to $900 range.
How much does a mold test kit cost?
The cost of mold test kits ranges from about $10 up to $395, with costlier kits typically including more tests and supplies like swabs, test plates and adhesive strips. Other services, such as lab analysis, can add as much as $40 to the total cost.
What does black mold smell like?
It's often described as musty and earthy, and may even smell like rotting vegetables or plants. You might notice a musty smell, but not be able to see any mold growing. In this case, you should look for areas that might be exposed to water.
What does mold poisoning feel like?
Primarily, mold illness is associated with allergic reactions that mimic seasonal allergies. Respiratory symptoms such as wheezing, coughing, watery eyes, and skin irritation are the predominant symptoms.
Does Walmart sell mold detectors?
First Alert MT1 Take Home Mold Detection Test Kit - Walmart.com.
Can black light detect mold?
While you can easily spot some mold by its moist, brown, black or gray appearance, some mold may not present itself to the naked eye, particularly if it lingers inside walls. A black light can help you spot this hidden mold.
How long does it take to get sick from mold exposure?
These symptoms usually first appear 2 to 9 hours after exposure and last for 1 to 3 days. Other affected persons have progressive shortness of breath and cough, as well as weight loss. Work-relatedness may only become apparent over long holidays if symptoms resolve and then recur on return to work.
How do you know if you have mold spores in the air?
To test for mold spores in the air you're breathing, you'll need to purchase a viable mold detection kit such as Seeml Labs' Mold Inspector in a Box. Most quality mold tests cost between $20 and $45. The entire testing process will take a few days.
Will a dehumidifier help with mold?
If the humidity in a room increases, mold will start growing in patches on walls, clothes, and more. So, to answer your question, dehumidifiers do NOT kill mold, but they do prevent it by reducing humidity. If you have a mold problem in your home, don't wait. Mold spreads as long as it has a water source.
Should you paint over mold?
Paint over mold does not kill it. Mold-resistant paint only works to proactively prevent mold, NOT reactively kill mold. Kilz and Zinsser make primers that claim to kill mold, but you should still remove the mold before using either of these products. There are mold-inhibiting additives you can add to paint.
How do you get rid of mold on walls permanently?
Simply mix one part bleach to four parts water. Using a damp cloth gently scrub and wipe the mould until the mould is gone. Once finished, dry the area well with a soft cloth.
Can you test for mold poisoning?
A blood test, sometimes called the radioallergosorbent test, can measure your immune system's response to mold by measuring the amount of certain antibodies in your bloodstream known as immunoglobulin E (IgE) antibodies.
Can mold grow in your lungs?
The mold spores can colonize (grow) inside lung cavities that developed as a result of chronic diseases, such tuberculosis, emphysema, or advanced sarcoidosis. The fibers of fungus might form a lump by combining with white blood cells and blood clots.
Does mold in your house make you tired?
Exposure to mold can cause you to feel very tired for many reasons. Respiratory problems like pneumonia can actually limit the amount of oxygen you can take in, which makes you feel tired.